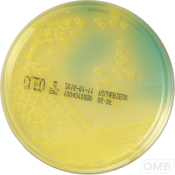
CLED Аgar - Агар для выделения   микроорганизмов из мочевого тракта
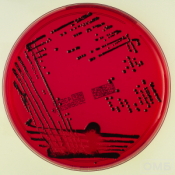
XLD Agar - Агар для селективного выделения Salmonella и Shigella
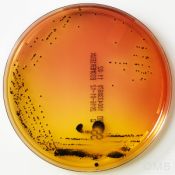
SS Agar - Агар для селективного выделения Salmonella и Shigella
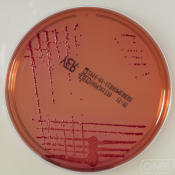
Yersinia CIN Agar - Агар для селективного выделения Yersinia

Оборудование для проведения преаналитических исследований
Для выполнения любого микробиологического исследования потребуются расходные материалы и оборудование. Среди них важными являются расходные материалы и оборудование для выполнения первого - преаналитического этапа (от приготовления питательной среды до получения чистой культуры).
В каталоге компании ОМБ представлен полный спектр расходных материалов и приборов для подготовительной работы:
- транспортные среды для доставки жизнеспособного материала в лабораторию;
- питательные среды (общего назначения, селективные, дифференциальные, хромогенные);
- приборы для автоматического приготовления питательных сред (бульонов и агаров);
- оборудование (разливочный модуль) для автоматического розлива приготовленных питательных сред;
- помпа для полуавтоматического розлива приготовленных питательных сред;
- оборудование (насос, присоединяемый к любому устройству, в котором приготовляется среда) для полуавтоматического розлива питательных сред;
- устройство для автоматического окрашивания мазков по Граму;
- микробиологические инкубаторы для выращивания чистых культур;
Работая в тесном сотрудничестве с ведущими мировыми производителями оборудования для микробиологии—компаниями bioMerieux SA (Франция) и Andreas Hettich GmbH (Германия), мы предлагаем нашим клиентам максимально комфортные коммерческие условия.
Наше оборудование для преаналитических исследований может быть использовано не только в клинической медицине, но и в центрах гигиены и эпидемиологии, в различных производственных лабораториях (пищевых, фармакологических, косметологических), в различных научно-исследовательских лабораториях и институтах. Мы предлагаем полностью автоматизированные решения, позволяющие максимально упростить и ускорить процедуру подготовки микробиологического материала к дальнейшему аналитическому исследованию.
Наше оборудование поможет вам повысить эффективность и качество исследований. Мы осуществляем оперативные поставки оборудование во все города России и обеспечиваем полноценную сервисную и методическую поддержку лабораторий. Звоните нам по телефонам, опубликованным на сайте и получайте детальную консультацию по всем вопросам, связанным с будущим сотрудничеством.

Нужен совет, как выбрать оборудование или использовать его?
Просто опишите ваши ожидания — эксперты Компании ОМБ подберут несколько подходящих товаров и подробно расскажут об их возможностях.
Связаться с нами можно по телефону
+7 495 925-81-50 или заполнив форму.

Внимание!
Размещенная на сайте www.omb.ru информация (в том числе рекламного характера), а также графические образы и изображения медицинских изделий представлены исключительно для сотрудников медицинских организаций/медицинских работников - пользователей медицинских изделий и поставщиков медицинских изделий.
Нажимая на кнопку «Продолжить» и оставаясь на указанном сайте, вы подтверждаете, что являетесь медицинским работником, либо поставщиком медицинских изделий и принимаете на себя ответственность за несоблюдение указанного ограничения.